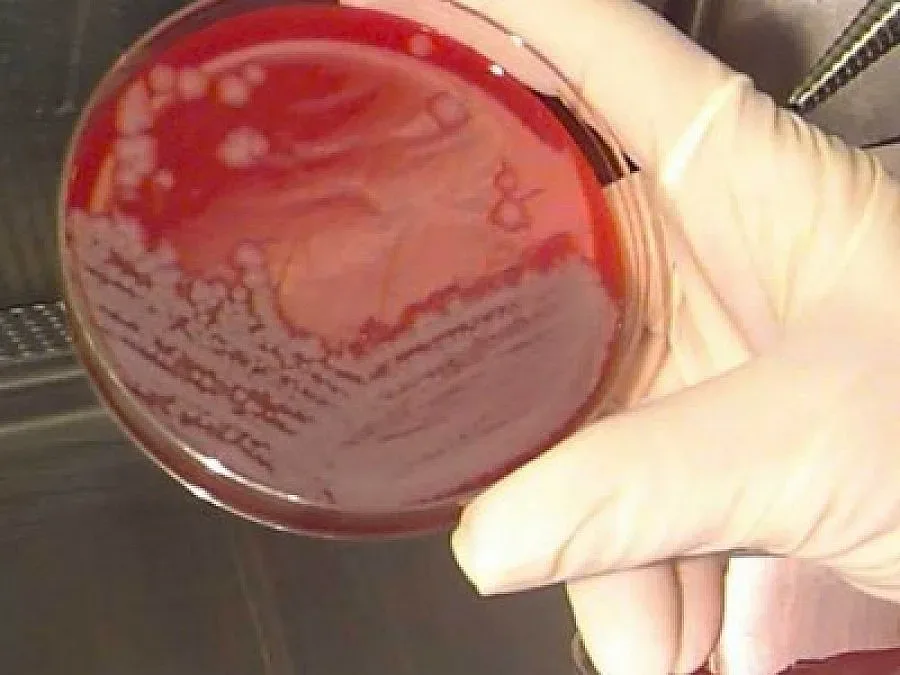

София
Специален тест може да открие рака преди той да се е появил. Това твърди доц. Влади Манев, председател на консултативния съвет по имунопрофилактика и имунотерапия на рака.
Изследвания, направени с биомаркер за инфекциозна мононуклеоза показват дали организмът има предразположение да развие ракови клетки.
9 от 10 човека са се срещали с вируса на мононуклеозата, който може да предизвика злокачествена промяна на клетките.
Хората със силна имунна система преборват вируса. При срив на имунитета обаче клетката взема генетичния код на вируса и започва да се видоизмня в злокачествена, обясни специалистът.
Той е изпратил писмо до здравния министър д-р Евгений Желев с молба да финансира изследвания на различни групи онкоболни, както и на здрави хора, за да се установи каква е причината за пробив на имунната система при някои хора и за отключване на нелечимото заболяване.
За изследване на 1500 души с научна цел са необходими 1 млн. евро, уточни доц. Манев.
Румяна Милева
Последвайте ни в Google News Showcase за важните новини
Вижте всички актуални новини от Standartnews.com